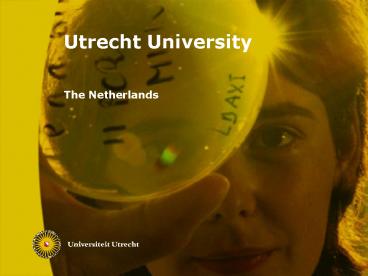

Utrecht University PowerPoint PPT Presentation
1 / 38
Title: Utrecht University
1
Utrecht University
- The Netherlands
2
Introduction
3
Utrecht University at a glance
- Outstanding international reputation as a leading
European research university - High-quality academic environment with a focus
on excellence - Innovative approach to both research and teaching
- High undergraduate success rate
- In the prestigious Shanghai Jiao Tong
University Academic Ranking of World
Universities (2007), Utrecht University is ranked
no. 1 in the Netherlands, no. 7 in Europe and no.
42 in the world.
4
Utrecht University at a glance
- Largest research university in the Netherlands
with a broad range of academic disciplines - Close collaboration between disciplines
- Comprehensive array of high quality
English-taught degree programmes and courses - Focus on knowledge transfer sharing knowledge
adds value - Committed to nurturing talent
5
Key figures 2006
- 7 Faculties
- 6 Graduate Schools
- 3 campuses in Utrecht and 1 campus in Middelburg
- 29295 enrolments 6530 first-year students
- 8321 staff (including Medicine)
- 48 Bachelors degree programmes (3 of which are
English-taught) and 197 Masters degree
programmes (89 of which are English-taught) - 443 PhDs granted
6
Key figures 2006
- 7275 scientific publications
- 73 of research programmes rated good to
excellent - Budget 700 million
- Founded in 1636
7
Utrecht University 7 faculties
- Geosciences
- Humanities
- Law, Economics and Governance
- Medicine / University Medical Center Utrecht
- Science
- Social and Behavioural Sciences
- Veterinary Medicine
8
Utrecht University 6 Graduate Schools
- Graduate School of Geosciences
- Graduate School of Humanities
- Graduate School of Law, Economics and Governance
- Graduate School of Life Sciences
- Graduate School of Natural Sciences
- Graduate School of Social and Behavioural Sciences
9
Research
10
Utrecht Universitys rankings
- In the 2007 Academic Ranking of World
Universities released by Shanghai Jiao Tong
University, Utrecht University is ranked - No. 42 in the world
- No. 7 in Europe
- No. 1 in the Netherlands
- The University's research in the science
disciplines ranks 4th in Europe, based on the
prestigious Excellence-ranking by the German
based Centre for Higher Education Development
(CHE).
11
Interdisciplinary knowledge and research
- Broad range of academic disciplines
- Interdisciplinary collaboration
- At the forefront of developments in
interdisciplinary research - Strong relationship between research and teaching
- Research alliances with business and industry
12
15 research focus areas
- Brain, Cognition and Behaviour
- Cardiovascular Research
- Conflicts and Human Rights
- Coordinating Societal Change
- Cultures and Identities
- Drug Innovation
- Earth and Sustainability
- Epidemiology
- Foundations of Natural Science
- Growth and Differentiation
13
15 research focus areas
- History and Philosophy of the Sciences and the
Humanities - Infection and Immunity
- Information Technologies in Science and Society
- Life Sciences and Biocomplexity from Molecules
to Organisms - Origins and Impact of Institutions
14
Nobel Laureates
- Utrecht University has 11 Nobel Prize winners,
including - 1999 Gerard t Hooft (Physics)
- 1999 Martinus J.G. Veltman (Physics)
- 1995 Paul Crutzen (Chemistry)
- 1981 Nicolaas Bloembergen (Physics)
- 1975 Tjalling Koopmans (Economic Sciences)
15
Spinoza laureates
- Utrecht University has 12 Spinoza Prize winners,
including - 2007 Prof. Deirdre Curtin (International and
European Governance) - 2006 Prof. Jozien Bensing (Clinical Psychology)
- 2006 Prof. Ben Scheres (Molecular Genetics)
- 2005 Prof. René Bernards (Molecular Biology)
- 2004 Prof. Jaap Sinninghe Damsté (Marine
Biogeochemistry and Toxicology) - 2003 Prof. Jan Luiten van Zanden (Economic and
Social History) - The annual Spinoza Prize is awarded by the
Netherlands Organisation for Scientific Research
(NWO)
16
Academy Professors (Royal Netherlands Academy of
Arts and Sciences, KNAW)
- Utrecht University has 4 Academy Professors
- 2003 Prof. Gerard t Hooft (Theoretical Physics)
- 2004 Prof. Hans Duistermaat (Fundamental and
Applied Mathematics) - 2005 Prof. Henk Lekkerkerker (Colloid Chemistry)
- 2007 Prof. Hans Oerlemans (Meteorology)
17
Committed to nurturing talent
- High potentials scheme for academic staff
- Talent development programme for non-academic
staff - Center of Excellence in University Teaching
- Academic Leadership programme
- Honours programmes for students
- Supporting academic staff in national
competitions for prestigious individual grants
18
Teaching
19
Key figures 2006
- 29295 enrollments and more than 2000 PhD students
- 125 nationalities
- 3 campuses in Utrecht and 1 campus in Middelburg
- 48 Bachelor's degree programmes, 3 of which are
English-taught - 197 Master's degree programmes, 89 of which are
English-taught - Some 200 certificate courses
- More than 50 Summer School courses
20
What Utrecht University has to offer
- Wide array of English-taught degree programmes
and courses - Best undergraduate success rate
- Honours programmes and Prestige Masters
programmes for talented students - Inspiring, ambitious, and international academic
environment - Strong link between research and teaching
- Small teaching groups and Colleges
- Broad range of student facilities
21
Support services for international students
- Scholarships for excellent students
- Guaranteed accommodation
- Priority visa processing arrangements
- International student orientation events
- Dutch mentor programme
- Erasmus Student Network activities
- Dutch Society and Culture course
- Dutch or English language courses
22
Support services for international students
- State-of-the-art study facilities
- Wide variety of cultural courses and excellent
sports facilities
23
Bachelors Masters programmes
24
English-taught Bachelors degree
programmeswww.uu.nl/internationalbachelors
- University College Utrecht (Liberal Arts and
Sciences) - Roosevelt Academy Middelburg (Liberal Arts and
Sciences) - BSc in Economics
25
English-taught Masters degree programmeswww.uu.n
l/internationalmasters
- 197 Masters programmes, 89 of which are
English-taught - 59 English-taught research degree programmes
preparing students for a research / PhD career - 21 English-taught degree programmes, preparing
students for a professional career
26
Exchange programmeswww.uu.nl/exchange
- 200 English-taught courses for short-stay
students - Exchange agreements with partner universities
across the world
27
Summer School courseswww.utrechtsummerschool.nl
- More than 50 academic courses at various levels
and in various disciplines - One of the largest summer schools in Europe
- Full and varied social programme
- Housing included
28
Knowledge transfer sharing knowledge adds value
29
Knowledge transfer
- Three imperatives, namely boosting, supporting
and - facilitating successful
- science-based entrepreneurship
- knowledge transfer between Utrecht University,
government and industry - strategic collaboration with regional players to
create an internationally competitive region
30
Entrepreneurship
- Science Park
- Centre for Entrepreneurship and Innovation
- One-stop shop for small and medium-sized
businesses - StartImpuls Utrecht (start up technology based
enterprises) - Utrecht University Holding Ltd and Incubator
- Entrepreneurship education
- Utrecht Centre for Education in Management and
Entrepreneurship (UCEME)
31
Entrepreneurship
- ICT Incubator Netherware for entrepreneurial
students - Utrecht School of Applied Sciences
- Centre of Entrepreneurship
32
Knowledge transfer
- Utrecht University Holding Ltd. (patents
spin-offs) - One-stop shop for small and medium-sized
businesses (access point) - Faculty-based science shops
- UniPartners student initiative
33
Collaboration
- Utrecht region
- Utrecht Innovation Taskforce
- Science Park
- Randstad North Wing region
- Peaks in the Delta (Immuno Valley en Game
Factory) - European Structural Funds (EFRO)
- EU
- League of European Research Universities (LERU)
- Worldwide Universities Network (WUN)
- Utrecht Network
34
Examples of major consortia and projects
- TI Pharma (FES, M 160)
- Knowledge for Climate (M 50)
- Aviaire Influenza bird flu (FES, M 15)
- Gate serious gaming (FES, M 10)
- CatchBio Catalysis (Smart Mix, M 28)
- Nanomedicine (KP6, M 16,3)
- Video Active creating access to Europes
television heritage (EU, M 2,7) - 7-Tesla MRI brain imaging (NWO-BIG, M 20)
35
Membership of university networks
- League of European Research Universities (LERU)
- Worldwide Universities Network (WUN)
- Utrecht Network
36
Utrecht city of culture
37
Utrecht City at a glance
- Lively student city located in the heart of the
Netherlands and gateway to Europe - Rich history going back almost 2000 years
- 300000 inhabitants
- 70000 higher education students
- Old city centre with picturesque canals,
canal-side cellars, ancient churches and
impressive Dom tower - Festival and cultural city
- Close relationship between Utrecht University and
the city of Utrecht
38
Utrecht University
- www.uu.nl